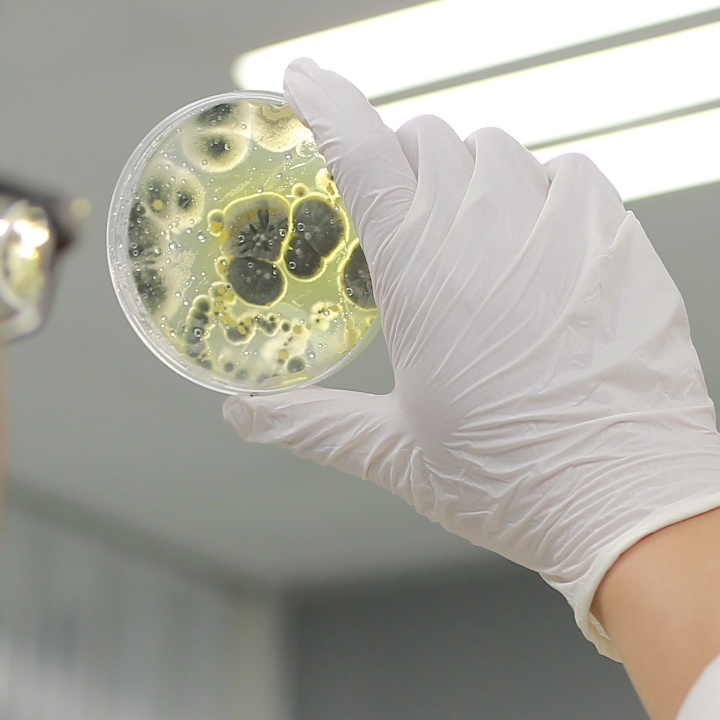
Group 121

Workshops
Certifications
Resources
Upcoming Events
Mold Myths Uncovered: Science, Truths, and Practical Solutions
30-minute session; scheduled upon full enrollment; date & time emailed
Address common mold-related issues to dispel misconceptions and provide evidence-based insights.(Chinese and English sessions are conducted separately. Kindly indicate your preferred language.)
Zoom (Online Event)

Frontiers of Mold Resistance: Science, Technology, and Strategy
30-minute session; scheduled upon full enrollment; date & time emailed
Explain the design principles of antifungal products, compare different types of antifungal solutions, and identify suitable application scenarios.(Chinese and English sessions are conducted separately. Kindly indicate your preferred language.)
Zoom (Online Event)

Smart Climate Strategies: Advanced Humidity Control for Mold Risk Management
30-minute session; scheduled upon full enrollment; date & time emailed
Introduce commonly used equipment in factories and illustrate, with practical examples, their interactions with fungal growth.(Chinese and English sessions are conducted separately. Kindly indicate your preferred language.)
Zoom (Online Event)

The Science of Mold Growth: Environments and Materials in Action
30-minute session; scheduled upon full enrollment; date & time emailed
Describe the three main factors influencing fungal growth and the understanding of mold risks associated with different materials.(Chinese and English sessions are conducted separately. Kindly indicate your preferred language.)
Zoom (Online Event)

Microbiology of Molds: Understanding the Invisible World
30-minute session; scheduled upon full enrollment; date & time emailed
Explain the differences among microorganisms, the basic concepts of fungi, fungal structures, and growth factors.(Chinese and English sessions are conducted separately. Kindly indicate your preferred language.)
Zoom (Online Event)
Past Events
Application and Selection of Anti-Mold Products
August 5 – 9, 2025
Online Event
Guidelines for Selecting Dehumidification, Ventilation, and Cooling Systems
July 29 – August 2, 2025
Boston, USA (In-Person)
Common Mold Prevention Methods
July 15 – 19, 2025
Online Event
Ventilation Systems as a Source of Mold Contamination
July 8 – 12, 2025
Mumbai, India (In-Person)
Material Structure and Mold Contamination
June 24 – 28, 2025
Taipei, Taiwan (In-Person)
Material Risk Classification
June 17 – 20, 2025
Boston, USA (In-Person)
Common Sources of Moisture and Risk Scenarios
June 3 – 7, 2025
Jakarta, Indonesia (In-Person)
The Relationship Between Humidity and Mold Germination
May 20 – 24, 2025
Online Event
The Impact of Temperature on Mold Growth
May 6 – 9, 2025
Ho Chi Minh City, Vietnam (In-Person)
Mold Rx: Safeguarding Medical Spaces with Science
April 9 – 30, 2025
Jakarta, Indonesia (In-Person)
Green Shield: Building a Mold-Free, Sustainable Future
March 12 – 28, 2025
Online Event
Mold Matters: Smart Strategies for Risk-Free Spaces
February 5 – 8, 2025
Taipei, Taiwan (In-Person)
January 10 – 14, 2025
Online Event
Fortify Spaces: Advanced
Mold Control in Work
Environments
December 5 – 9, 2024
Boston, USA
The Mold Blueprint:
Designing Future-Proof
Solutions
November 15 – 20, 2024
Jakarta, Indonesia
Think Clean: Intelligent
Mold Management Systems
October 3 – 7, 2024
Online Event
Global Mold Trends: Lessons
from Across the World
September 12 – 16, 2024
Mumbai, India
Engineering Resilience:
Mold Prevention in
Industrial Settings
August 8 – 12, 2024
Ho Chi Minh City, Vietnam
Ready to join the fight against mold?
Contact us to book your session
and stay ahead in this ever-evolving field.